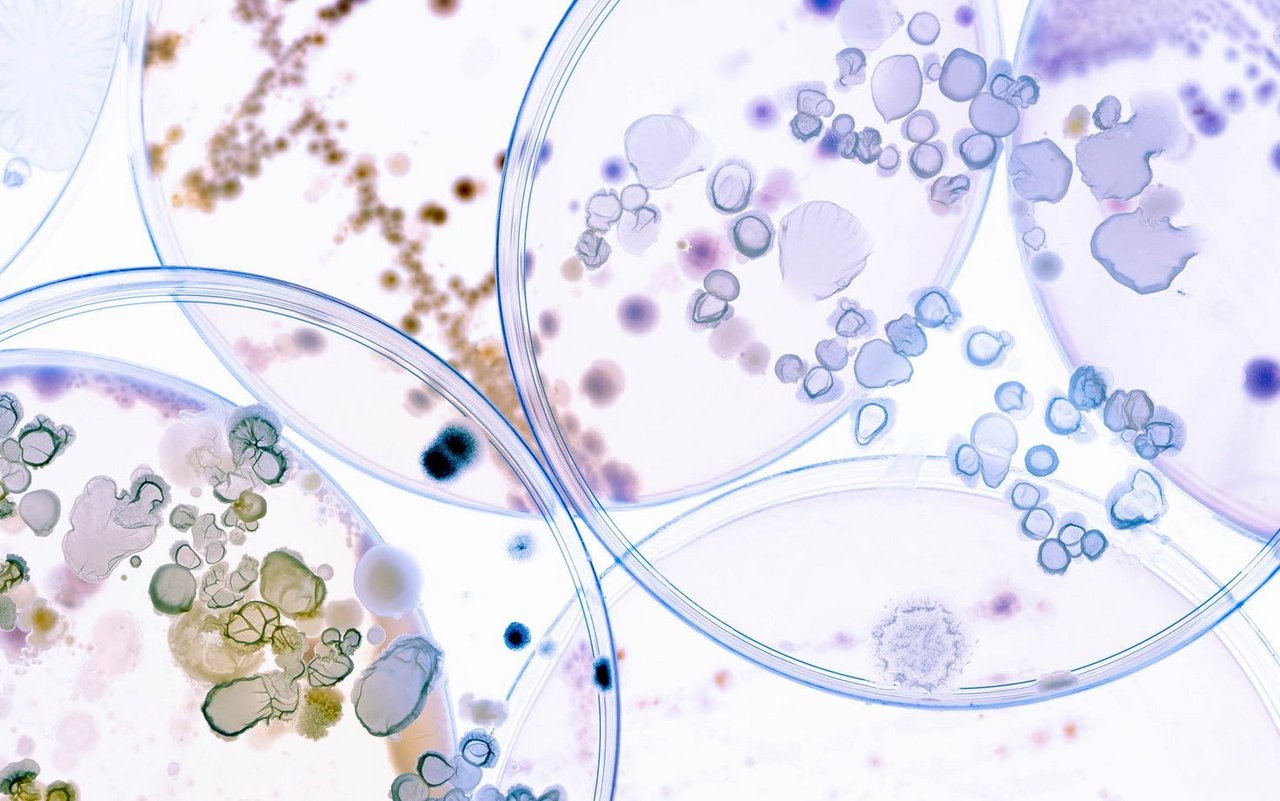
Zoonosen kommen in der Schweiz selten, aber regelmässig vor.

Zoonosen
Von Tieren auf den Menschen übertragbare Krankheiten
Auch in der Schweiz gibt es Krankheiten, die von Tieren auf den Menschen übertragbar sind. Alle Infos zu den wichtigsten Zoonosen.
Campylobacteriose
Erreger: Bakterien der Gattung Campylobacter. Natürliche Wirte sind Wildtiere (Vögel, Nagetiere), Nutztiere (Geflügel, Vieh) und Haustiere (Hunde, Katzen)
Übertragung: Durch kontaminierte Lebensmittel wie z.B. ungenügend erhitztes Fleisch, insbesondere Geflügel, verunreinigtes Wasser und nicht pasteurisierte Milch. Direkter Kontakt mit Tieren, welche das Bakterium tragen. Übertragung von Mensch zu Mensch möglich, aber selten.
Krankheitsbild: Oft asymptomatisch. Ansonsten Durchfall, Bauchschmerzen, Erbrechen und Fieber. Betroffene erholen sich in der Regel innerhalb ein bis zwei Wochen. Komplikationen sind selten.
Häufigkeit: In der Schweiz werden jährlich zwischen 7000 und 8000 Campylobacter-Erkrankungen gemeldet.
Vorbeugung: Konsequente Küchenhygiene, insbesondere bei der Zubereitung von Geflügel. Durchgaren von Fleisch. Abkochen von Rohmilch. Regelmässiges Händewaschen.
Listeriose
Erreger: Listeria monocytogenes, ein Bakterium, das praktisch überall in der Natur vorkommt.
Übertragung: Listeriose-Bakterien werden prinzipiell durch Lebensmittel, insbesondere tierischer Herkunft übertragen. Dazu gehören Fleisch und Wurstwaren, Fisch, Rohmilch und Milchprodukte). Aber auch pflanzliche Lebensmittel wie vorgeschnittene Salate kommen in Frage.
Krankheitsbild: Bei Personen mit normalen Abwehrkräften verläuft die Infektion oft symptomlos oder mit nur milden Krankheitsanzeichen wie grippeähnlichen Symptomen. Bei Personen mit geschwächtem Immunsystem können sich schwere Symptome wie Hirnhautentzündung, Lungenentzündung oder Blutvergiftung entwickeln. Bei Schwangeren besteht die Gefahr vorzeitiger Wehen mit einem entsprechend erhöhten Risiko einer Früh- oder Totgeburt.
Häufigkeit: In der Schweiz werden jährlich bis zu 100 Fälle gemeldet.
Vorbeugung: Gute Küchenhygiene, Beachten der Lagerungstemperatur und des Haltbarkeitsdatums. Personen mit geschwächtem Immunsystem und Schwangere sollten Rohkost, rohes oder halbgares Fleisch, rohen Fisch und Meerestiere, sowie Käse aus nicht pasteurisierter Milch meiden.
Coxiellose (Q-Fieber)
Erreger: Coxiella burnetii, ein Bakterium, das bei Rindern, Schafen, Ziegen, Hunden, Katzen, einigen Wildtieren, sowie Zecken vorkommt.
Übertragung: Infizierte Tiere zeigen keine Symptome, scheiden den Erreger aber über Kot, Urin und Milch aus. Zur Infektion beim Menschen kommt es meist durch das Einatmen von erregerhaltigem Staub oder dem direkten Kontakt mit einem infizierten Tier.
Krankheitsbild: Bei den meisten Personen kommt es zu keinen oder nur milden Symptomen. In rund der Hälfte der Fälle bekommen Betroffene Fieber, Schüttelfrost, Schweissausbrüche und Kopfschmerzen. Trockener Husten und Brustschmerzen sind häufige Begleiter der Krankheit. Bei manchen Erkrankten kann es zu Komplikationen wie Herz-, Lungen- oder Leberentzündungen kommen.
Häufigkeit: In der Schweiz kommt es jährlich zu 40 bis 100 gemeldeten Fällen.
Vorbeugung: Die meisten präventiven Massnahmen liegen im Bereich der Veterinärmedizin, also dem Verhindern einer Erkrankung der Tiere. In manchen stark betroffenen Ländern gibt es die Möglichkeit einer Impfung, diese ist allerdings in der Schweiz nicht zugelassen.
Salmonellose
Erreger: Bakterien der Gattung Salmonella. Träger sind Schweine, Rinder, Geflügel und Reptilien.
Übertragung: Die Übertragung auf den Menschen erfolgt über kontaminierte Lebensmittel wie Eier, Fleisch und Milch, oder durch mit Fäkalien verunreinigtes Wasser.
Krankheitsbild: Abrupt beginnende Durchfälle, Bauchschmerzen und Erbrechen Stunden bis Tage nach einer Ansteckung.
Häufigkeit: In der Schweiz werden jährlich zwischen 1200 und 2000 Labornachweise von Salmonellen gemeldet.
Vorbeugung: Gute Küchenhygiene, insbesondere beim Verarbeiten von rohen Eiern.
Brucellose (Maltafieber)
Erreger: Bakterien der Gattung Brucella. Verschiedene Arten des Bakteriums kommen bei Schafen, Ziegen, Schweinen, Rindern und Hunden vor.
Übertragung: Zu einer Infektion kann es durch den Genuss von verunreinigten Lebensmitteln, insbesondere nicht pasteurisierter Milch, kommen. Auch eine direkte Übertragung durch den Kontakt mit infizierten Tieren und deren Ausscheidungen ist möglich. Eine Übertragung von Mensch zu Mensch ist nicht nachgewiesen.
Krankheitsbild: 90 Prozent der Infektionen verlaufen symptomlos. Bei manchen Betroffenen kommt es zu grippeähnlichen Symptomen wie Fieber und Schüttelfrost, sowie zu Schwellungen von Leber, Milz und Lymphknoten.
Häufigkeit: In der Schweiz sind Rinder, Schafe, Ziegen und Schweine frei von Brucellose. Entsprechend werden lediglich ein bis zehn Fälle pro Jahr gemeldet.
Vorbeugung: Produkte aus nicht pasteurisierter Milch aus stärker betroffenen Regionen (Mittelmeerraum, Naher Osten, Afrika, Zentralasien, Lateinamerika) meiden.
Echinokokkose
Erreger: Fuchsbandwurm (Echinococcus multilocularis), welcher selten auch im Darm von Hunden und Katzen lebt.
Übertragung: Die Eier des Bandwurms werden von Füchsen über den Kot ausgeschieden und können in feuchter Umgebung monatelang überleben. Menschen stecken sich durch rohe Lebensmittel oder Trinkwasser an, wenn diese mit den Eiern des Fuchsbandwurms verunreinigt sind.
Krankheitsbild: Die Larven des Fuchsbandwurms entwickeln sich im Dünndarm einer infizierten Person und gelangen über den Blutweg in die Leber. Hier bilden sie Zysten und beinträchtigen somit die Funktion des Organs. Die Erkrankung wird oft erst nach Monaten bis Jahren entdeckt und kann in den meisten Fällen behandelt werden.
Häufigkeit: Pro Jahr gibt es in der Schweiz 10 bis 20 Neuerkrankungen.
Vorbeugung: Bodennah wachsende Waldfrüchte (Beeren, Pilze), sowie Gemüse, Salat und Beeren aus dem Garten vor dem Verzehr gründlich waschen. Tiefgefrieren tötet die Eier des Fuchsbandwurms nicht ab. Haustiere regelmässig entwurmen.

Bitte loggen Sie sich ein, um die Kommentarfunktion zu nutzen.
Falls Sie noch kein Agrarmedien-Login besitzen:
Jetzt registrieren